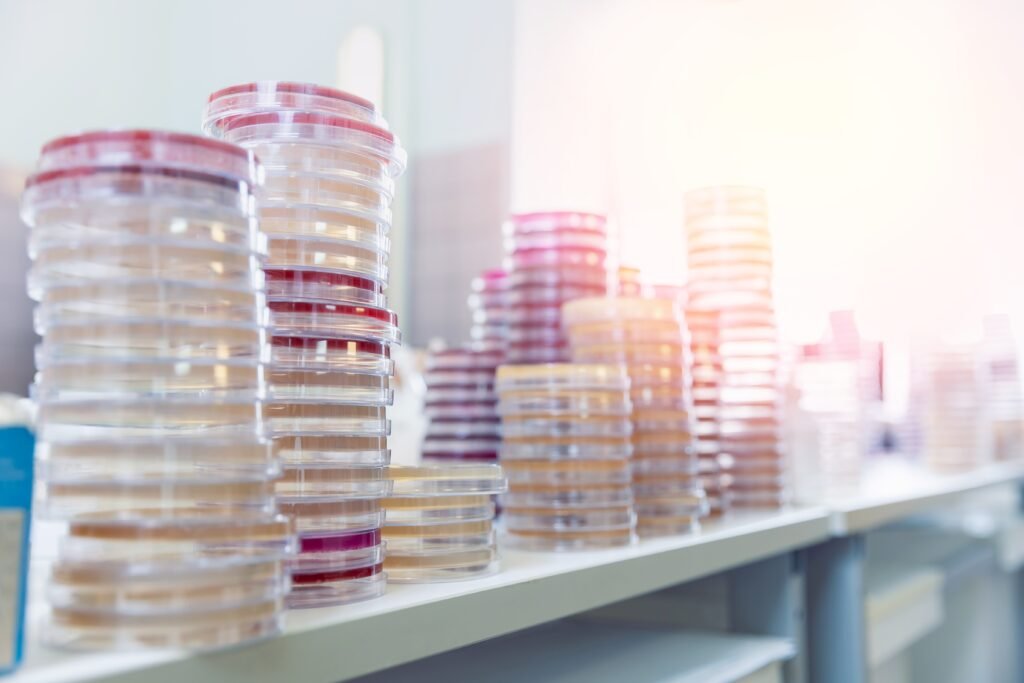

Atualizações Regulatórias para Controle Microbiológico na Indústria: Preparando-se para o Futuro
No dinâmico cenário industrial – seja farmacêutico, alimentício, cosmético ou veterinário – a microbiologia é um pilar inegociável para a segurança e a qualidade dos







